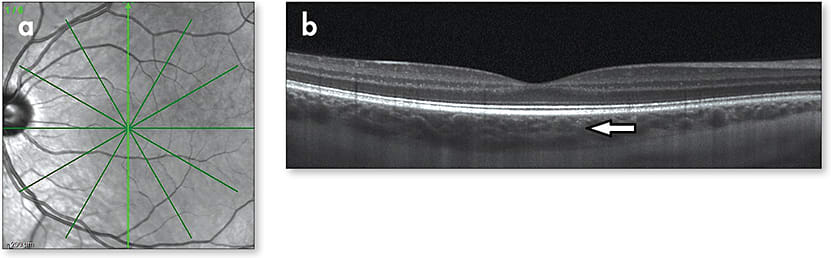

REFRACTIVE FOCUS
THE CHOROID AND REFRACTIVE ERROR DEVELOPMENT
DAVID A. BERNTSEN, OD, PHD

A significant number of studies have investigated optical interventions to slow the progression of myopia. Bifocal spectacles, bifocal soft contact lenses, and orthokeratology have all been evaluated as potential ways to slow myopia progression in children. While the myopia slowing effects of spectacle designs such as progressive addition lenses (PALs) have generally been small (Gwiazda et al, 2003), contact lenses have shown more promise.
A randomized clinical trial demonstrated that orthokeratology lens wear significantly slowed myopia progression by 43% over two years (Cho and Cheung, 2012). While a recent clinical trial utilizing a novel soft bifocal contact lens design found a modest two-year effect of 25% overall, children who wore who wore their lenses for at least six hours per day had a 50% effect (Lam et al, 2014). These results support the continued investigation of soft bifocal contact lens designs for controlling the progression of myopia in children.
A National Institutes of Health (NIH)-funded three-year clinical trial called the Bifocal Lenses in Nearsighted Kids (BLINK) Study is currently in progress to determine the efficacy of commercially available soft bifocal contact lenses with different add powers, though results are still a few years away.
Extensive work in animal models has established that visual feedback can guide ocular growth (for a review, see Smith, 2011). Myopic defocus (light focused in front of the retina) is known to be a potent “stop” signal for eye growth, while hyperopic defocus (light focused behind the retina) is a known “grow” signal.
So, how does the eye respond to defocus and signal changes in eye growth? As recent research is showing us, the human choroid responds to short-term defocus. Let’s look more closely at the choroid.
The Choroid’s Response to Defocus
We have known for quite some time that the choroid in animals responds to defocus. Located between the retinal pigmented epithelium (RPE) and the sclera (Figure 1), changes in choroidal thickness can make small changes in the plane of the retina. In multiple animal models ranging from the chick to the macaque monkey, the choroid has demonstrated a quick response to the sign of retinal defocus (Wallman et al, 1995; Hung et al, 2000). When presented with myopic defocus (light focusing in front of the retina), the choroid thickens, thus moving the retina in the direction of the focal plane. When presented with hyperopic defocus (light behind the retina), the choroid thins, moving the retina back toward the focal plane. So, if this happens in animals, what about humans?
Figure 1. Star OCT scan pattern used in several studies to collect multiple OCT B-scans to assess choroidal changes in children (a); individual OCT image showing the retina and choroid (arrow) (b).
Advances in imaging have allowed for the measurement of small, micron-level changes in the choroid. Read and colleagues (2010) reported that the human choroid predictably exhibits bidirectional responses to defocus. Over the course of 60 minutes, the human choroid thickens when exposed to myopic blur, causing a decrease in axial length, and the choroid thins when exposed to hyperopic blur, resulting in an increase in axial length. While these changes are small (on the order of 10 microns), they demonstrate a short-term response to the sign of defocus in the human eye.
Subsequent studies have confirmed these findings. Chiang et al (2015) observed choroidal thickness changes within 10 to 20 minutes of being exposed to defocus. These changes suggest a mechanism by which the human choroid is either actively or passively involved in signaling changes in eye growth to the sclera. The choroid of myopic children is also thinner than that of non-myopic children, and the difference is more than expected simply due to the longer axial length of myopic eyes (Read et al, 2013).
Increased time spent outdoors can protect against myopia onset in children (Jones et al, 2007; Rose et al, 2008). Several large studies have consistently found this protective effect of outdoor time against myopia onset; however, it is not clear whether outdoor time slows myopia progression once a child becomes myopic (Jones-Jordan et al, 2012). (Also, see my April 2016 Refractive Focus column titled “Two Hours Outdoors a Day Helps Keep Myopia Away” for a more thorough review of the outdoor myopia literature.)
In their longitudinal Role of Outdoor Activity in Myopia (ROAM) Study, Read and colleagues found that children who routinely experienced higher light levels throughout the day had significantly more thickening of the choroid over time compared to children who were exposed to lower levels of light exposure throughout the day (Read, 2016). More work is needed to better understand the role of choroidal thickness and light levels in eye growth. So, how might choroidal thickness factor into the slowed myopia progression found with optical designs?
Orthokeratology and the Choroid
Orthokeratology has demonstrated an ability to consistently slow eye growth by 36% to 55% (Cho et al, 2005; Kakita et al, 2011; Walline et al, 2009; Cho and Cheung, 2012). We also know that once fitted with orthokeratology lenses, myopic eyes that previously had peripheral hyperopic defocus before orthokeratology have peripheral myopic defocus after initiating orthokeratology (Kang and Swarbrick, 2011).
In a randomized study utilizing a partial-reduction orthokeratology methodology in children who had high amounts of myopia, an even larger treatment effect of 63% was found over two years (Charm and Cho, 2013). In that study, children who had –5.00D or more of myopia wore orthokeratology lenses that corrected about 4.00D of their myopia; spectacles were worn during the day to correct the residual myopia. The larger treatment effect in this partial-reduction orthokeratology study might have been due to a larger myopic shift in the periphery of the eye resulting from greater midperipheral corneal steepening that is associated with correcting higher amounts of myopia with orthokeratology lenses.
This hypothesis is supported by a study finding that myopic eyes with greater peripheral corneal power changes due to orthokeratology experienced slower axial eye growth (Zhong et al, 2014). Because myopic peripheral defocus is hypothesized to be the mechanism by which orthokeratology slows myopia progression, this begs the question: Does choroidal thickness change after orthokeratology contact lens wear?
Chen and colleagues (2016) just reported on 77 myopic children who were followed for three weeks in a non-randomized study; 39 children were fitted with orthokeratology lenses, and 38 wore spectacles. After three weeks, choroidal thickness in the orthokeratology-wearing children increased on average by 21.8 microns, while the average change in the spectacle group was negligible (0.1 microns).
Thus, it is possible that the myopic peripheral defocus caused by orthokeratology resulted in an increase in choroidal thickness. More work is needed to determine whether these changes in choroidal thickness are associated with future myopia progression.
More to Come
The choroid is currently a hot topic in myopia research. Knowing that the human choroid is able to respond to the sign of retinal defocus leads to many questions. More work is needed to better understand the choroid’s role in myopia progression. CLS
To obtain references for this article, please visit www.clspectrum.com/references and click on document #252.
Dr. Berntsen is an associate professor at the University of Houston College of Optometry. He is a Fellow of the American Academy of Optometry and conducts research on myopia progression, contact lenses, and aberrations of the eye. He has received research funding from Johnson & Johnson Vision Care and Bausch + Lomb.



